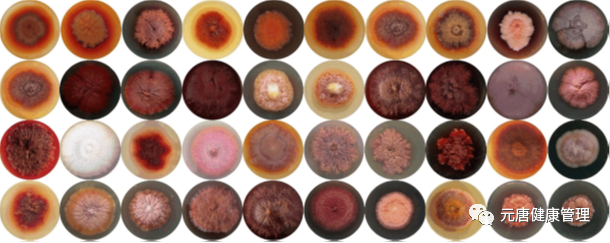
2.png

对红曲的好奇,始于对日本科学家远藤章的钦佩。

这位伟大的微生物发酵工程师从自己的一个假想出发,对几千种真菌进行筛选,经历了数千次的重复与失败,最终从红曲菌发酵液中找到了能够抑制胆固醇合成的他汀类物质。
所以,当得知能够有机会去雅安迅康药业看看雪瑞安红曲的发酵车间,我兴冲冲地赶去了成都。
肖总带领我们从成都驱车两个多小时到达雅安芦山县,一路飘着细雨,青衣江畔还能看到夏季芦山大雨时因水位暴涨留下的痕迹。
两岸山上植被茂密,自然环境极其优越,这里是多种野生动物栖息地,第一只野外大熊猫就是在这附近发现的。
芦山号称“天府之肺”,是长江上游重要生态屏障,常年空气温和湿润,洁净度高,故而,这里也是进行菌种发酵的好地方。

雅安迅康的另一个产品青黛的原料马蓝种植基地就在这儿。
绕过一段因8月份芦山暴雨冲毁的路段,我们抵达了迅康药业,几个发酵车间和青衣美人标准茶生产线都建在这里。
肖总告诉我们这儿曾经是一片水塘,4.20芦山地震后,为支持灾区重建,一群有情怀的迅康人填水塘、平地基、起高楼,建造了这座现代化药厂。

古法红曲的起源
红曲是我国先民巧夺天工的伟大发明,是祖国宝贵的科学文化遗产。
在唐代徐坚的《初学记》一书中有:王粲七释曰“西旅游梁,御宿素粲,瓜州红曲,参糅相拌,软滑膏润,入口流散”。
故多数史学者认为,在汉、魏时代就有红曲存在与利用了。
元代以后,《居家必用事类全集》、《墨娥小录》、《本草纲目》、《天工开物》等都记载有红曲详细的制法。
明代李时珍在《本草纲目》是这样评价红曲的:“此乃人窥造化之巧者也”,“奇药也”,在许多古代中药典集中均记载该品具有活血化瘀、健脾消食等功效。
千年来红曲一直用于治疗食积饱胀、产后恶露不净、瘀滞腹痛和跌打损伤等症。

功能性红曲的来源
直到远藤章从紫红曲霉中分离出了monacolins 类物质以后,科学家们经过大量的工作筛选出了可以代谢产生天然他汀的红曲菌,又将野生菌种驯化为生产菌种,使之能产生含量高、质量稳定、适合药用的天然他汀类物质。
同时还可以产生许多对人体有益的成分,含有丰富的生物活性酶和多种生理活性物质如麦角固醇、γ-氨基丁酸、天然植物激素等等。
红曲与古代红曲和一般仅作为色素的红曲都有了很大的区别,至此,我们有了功能性红曲。
通过敬老师的讲解,我们了解到红曲的发酵并不简单,传承于古法,但更多的是创新,发酵工艺质量控制点多达几百个。
一、菌种筛选
并非所有的红曲菌都具有他汀合成能力。
我们的菌种来自国家菌保中心,经两年的培育、驯化,育种,在获得高产他汀能力的同时,丧失桔霉素产生能力,从而得到高产安全的菌种。
40 株红曲霉菌株的菌落形态(参考文献:蒋冬花,丁曼青等.不同来源红曲霉菌株的鉴定和代谢产物多样性分析.[J]浙江师范大学学报,2020,43(4):410-416)
二、发酵稻米的选择
传统红曲米均是以大米作为原料,其较高的淀粉含量及较好的保湿性很适合红曲菌生长及代谢产物合成。

但大米种类繁多,不同品系、不同产地的大米存在一定差异,不但他汀产量不同,还有可能带入有害杂菌和重金属污染物。
通过反复试验,最终选定了新鲜优质五常大米做为发酵基质,从根源减少黄曲霉菌的污染,严控重金属含量超标。

四、翻料
敬老师告诉我们雪瑞安红曲采用小袋发酵,袋口覆以半透膜。然而,这20天里,大米并不是待在那里静静的发酵,每天都有药工定时进入32度恒温、恒湿的车间对它进行几次翻动。
我们都震撼于这个工作量的巨大,纷纷请教敬老师,这道工序难道不能用机器完成吗?敬老师告诉我们,翻动强度大了,会损伤菌丝,影响继续发酵;翻动的太轻,又会造成物料结团,发酵不透。
唯有药工用熟练、温柔的双手能够让大米达到最佳发酵状态。
当然,在翻动的同时,发酵中的红曲也会被那一双双锐利的眼睛审视,凡是发酵不达标的会随时被果断挑出,这严格的过程会一直持续到发酵完成。
可以说我们拿到的每一粒红曲在装袋前都经历了上百次严苛的挑选。
经过二十多天的等待,一批大米蜕变成了功能性红曲,古老的红曲在这里焕发了新的活力,做为天然药物中抑制胆固醇合成和降血脂的首选成分,照亮了高血脂、脂肪肝患者的健康之路。
后 记
我们临走这天下午,恰逢央视匠心栏目组来到雅安,在迅康药业拍摄属于雪瑞安红曲的匠心故事,期待节目的播出,期待从红曲发酵的匠心精神里,带给我们的健康力量。
